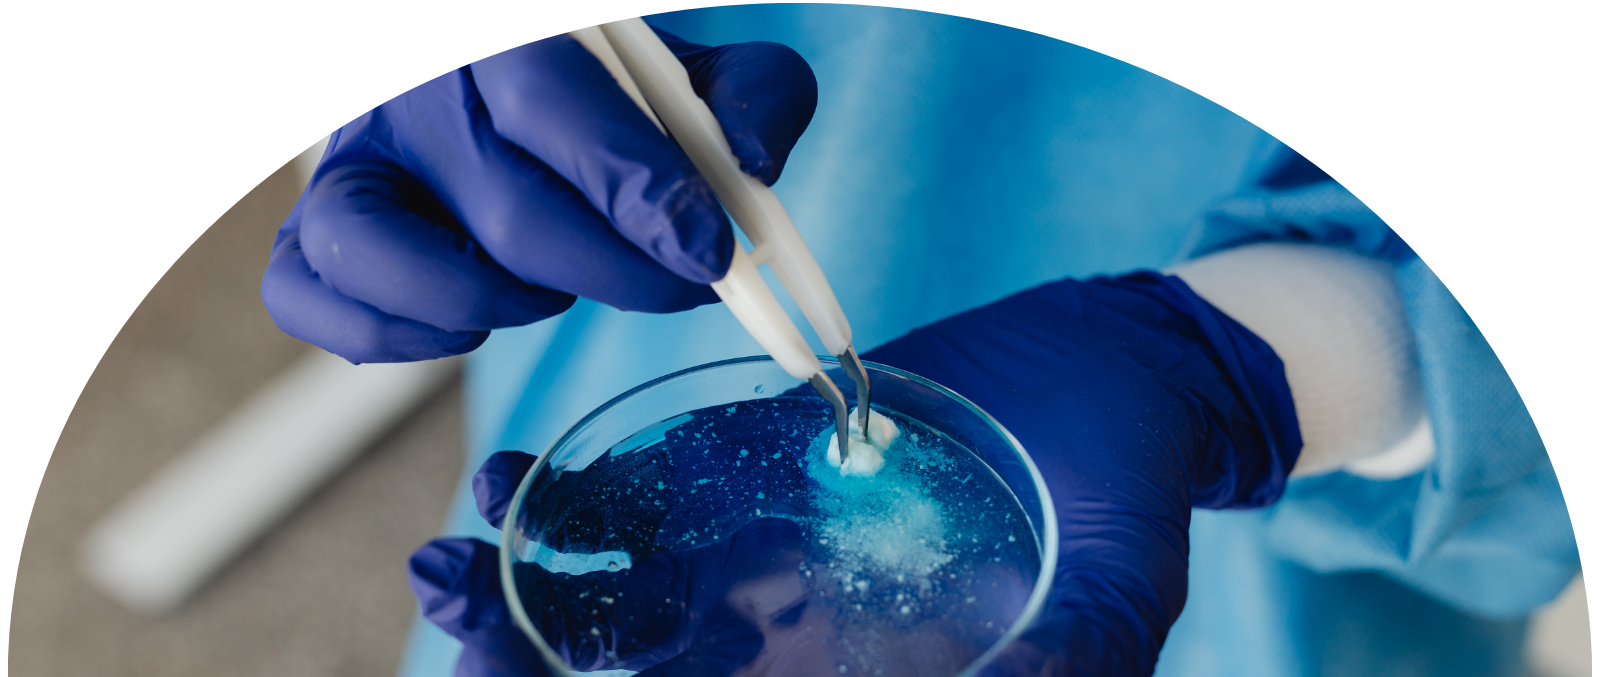

Control de calidad de grado de investigación
Control de calidad de grado de investigación
En Biozense, nuestros productos se suministran exclusivamente para estudios científicos y de laboratorio. La calidad se verifica mediante rigurosas pruebas analíticas y documentación.
Los pilares de calidad de Biozense
Nuestro enfoque de TQM garantiza resultados de investigación consistentes. Consulte el radar a continuación para ver nuestras áreas de enfoque principales.

Pureza
Verificación de pureza ≥99% mediante cromatografía líquida de alto rendimiento (HPLC).
Estado de la métrica
>99% verificado
Documentación
Proporcionar informes completos de MS y HPLC para cada lote para garantizar la transparencia para los investigadores.
Estado de la métrica
Informes específicos de lotes
Cumplimiento
Estricta adhesión a la distribución no médica y al etiquetado científico responsable.
Estado de la métrica
Cumple con la normativa
Estabilidad
Prueba de integridad estructural bajo diversas condiciones de almacenamiento para garantizar la consistencia de la investigación.
Estado de la métrica
Estabilidad en almacenamiento comprobada
Acceder a la documentación analítica
La transparencia es nuestra prioridad. Brindamos acceso al Certificado de Análisis (COA) y a los datos de MS/HPLC a nuestros investigadores para garantizar la integridad de sus estudios científicos.
- Verificado por terceros: pruebas de laboratorio independientes para obtener resultados imparciales.
Específico del lote: la documentación coincide con el lote exacto que recibe.
📊
HPLC
Análisis de pureza
🧬
MS
Espectrometría de masas
📑
COA
Documentación completa
🛡️
ISO
Operaciones estandarizadas
